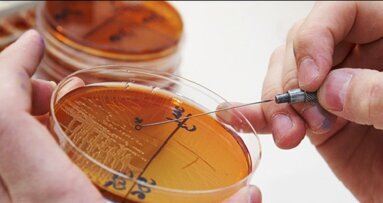
Καρκίνος κεφαλής και τράχηλου. Νέο σύστημα απλοποιεί τον θεραπευτικό σχεδιασμό

Το σύστηµα Snap–On Abutment µπορεί να χρησιµοποιηθεί τόσο σε πρόσθιες όσο και σε οπίσθιες περιοχές του στόµατος για συγκολλούµενες µονήρεις επι-εµφυτευµατικές στεφάνες. ∆ιατίθεται σε ύψη των 4mm και 5mm. Χάρις στο σχεδιασµό του προφίλ του, καθώς και τον άξονα αποτύπωσης που κουµπώνει πάνω στο abutment (στήριγµα), το σύστηµα Snap–On Abutment επιτυγχάνει αποτελεσµατικά το σκοπό για τον οποίο σχεδιάστηκε: την εύκολη απροβληµάτιστη χρήση.
Το σύστηµα Snap–On Abutment µπορεί να χρησιµοποιηθεί ως το τελικό abutment (στήριγµα) κατά την τοποθέτηση του εµφυτεύµατος ή µπορεί να χρησιµοποιηθεί ως µεταβατικό στο ιατρείο µε την εφαρµογή του Snap–On Temporary Cap. Το σύστηµα Snap–On Abutment διαθέτει το κοίλο (concave) προφίλ ανάδυσης που επιτρέπει την αύξηση του όγκου του µαλακού ιστού και εξασφαλίζει έτσι τη φυσική αισθητική και το άριστο βιολογικό αποτέλεσµα. Το σύστηµα Snap–OnAbutment διατίθεται σε συσκευασία που περιλαµβάνει όλα τα απαραίτητα µέρη για την ολοκληρωµένη προσθετική αποκατάσταση.
Διαβάστε περισσότερα εδώ
Η Αμερικανική Υπηρεσία ...
Γιατροί και ειδικοί στους ...
Η Curasept είναι μία πρωτοπόρος ιταλική εταιρεία που έχει ως στόχο τη βελτίωση της ...
Το σύστημα CEREC καλύπτει ένα ...
Δεν εμφανίζεται περιεμφυτευματίτιδα έως και 12 έτη μετά – αυτό είναι το πιο ...
Έχουν περάσει 38 χρόνια από τότε ...
Η μαλακή-ελαστική τελική ...
Τα χρηστικότερα πληροφοριακά ...
Live webinar
Τρι. 23 Ιουνίου 2026
3:00 πμ (EET) Athens
Live webinar
Τρι. 23 Ιουνίου 2026
8:00 μμ (EET) Athens
Live webinar
Τρι. 23 Ιουνίου 2026
10:00 μμ (EET) Athens
Live webinar
Τετ. 24 Ιουνίου 2026
3:00 μμ (EET) Athens
Live webinar
Τετ. 24 Ιουνίου 2026
6:00 μμ (EET) Athens
Live webinar
Τετ. 24 Ιουνίου 2026
7:30 μμ (EET) Athens
Dr. med. dent. Britta Hahn
Live webinar
Πεμ. 25 Ιουνίου 2026
9:00 μμ (EET) Athens
Dr. Hatem Algraffee, Cat Edney



 Αυστρία / Österreich
Αυστρία / Österreich
 Βοσνία και Ερζεγοβίνη / Босна и Херцеговина
Βοσνία και Ερζεγοβίνη / Босна и Херцеговина
 Βουλγαρία / България
Βουλγαρία / България
 Κροατία / Hrvatska
Κροατία / Hrvatska
 Τσεχία & Σλοβακία / Česká republika & Slovensko
Τσεχία & Σλοβακία / Česká republika & Slovensko
 Γαλλία / France
Γαλλία / France
 Γερμανία / Deutschland
Γερμανία / Deutschland
 Ελλάδα / ΕΛΛΑΔΑ
Ελλάδα / ΕΛΛΑΔΑ
 Ουγγαρία / Hungary
Ουγγαρία / Hungary
 Ιταλία / Italia
Ιταλία / Italia
 Ολλανδία / Nederland
Ολλανδία / Nederland
 Σκανδιναβικές χώρες / Nordic
Σκανδιναβικές χώρες / Nordic
 Πολωνία / Polska
Πολωνία / Polska
 Πορτογαλία / Portugal
Πορτογαλία / Portugal
 Ρουμανία & Μολδαβία / România & Moldova
Ρουμανία & Μολδαβία / România & Moldova
 Σλοβενία / Slovenija
Σλοβενία / Slovenija
 Σερβία & Μαυροβούνιο / Србија и Црна Гора
Σερβία & Μαυροβούνιο / Србија и Црна Гора
 Ισπανία / España
Ισπανία / España
 Ελβετία / Schweiz
Ελβετία / Schweiz
 Τουρκία / Türkiye
Τουρκία / Türkiye
 Ηνωμένο Βασίλειο & Ιρλανδία / UK & Ireland
Ηνωμένο Βασίλειο & Ιρλανδία / UK & Ireland
 Διεθνές / International
Διεθνές / International
 Βραζιλία / Brasil
Βραζιλία / Brasil
 Καναδάς / Canada
Καναδάς / Canada
 Λατινική Αμερική / Latinoamérica
Λατινική Αμερική / Latinoamérica
 Η.Π.Α. / USA
Η.Π.Α. / USA
 Κίνα / 中国
Κίνα / 中国
 Ινδία / भारत गणराज्य
Ινδία / भारत गणराज्य
 Πακιστάν / Pākistān
Πακιστάν / Pākistān
 Βιετνάμ / Việt Nam
Βιετνάμ / Việt Nam
 ASEAN / ASEAN
ASEAN / ASEAN
 Ισραήλ / מְדִינַת יִשְׂרָאֵל
Ισραήλ / מְדִינַת יִשְׂרָאֵל
 Αλγερία, Μαρόκο & Τυνησία / الجزائر والمغرب وتونس
Αλγερία, Μαρόκο & Τυνησία / الجزائر والمغرب وتونس
 Μέση Ανατολή / Middle East
Μέση Ανατολή / Middle East

To post a reply please login or register